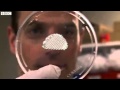
3D 바이오 프린터의 탄생

3D 바이오 프린터의 탄생
우리는 이미 지상에 진정한 낙원을 만들기위한 경건한 기술을 이미 가지고 있거나 곧 갖게 될 것입니다. 일과 돈이없고 질병도없는 낙원. 오늘날 우리 과학자들은 신체 부위 용 3D 프린터를 개발하고 있습니다. 이 기술을 사용하면 모든 기능 장애 또는 노화 된 신체 부위를 언젠가 교체 할 수 있습니다. 그것은 젊은 몸에 사는 것과 같을 것입니다 … 영원히.
하나의 장기가 아니라 전신을 3D 프린팅하고 인간의 탄소 복사 (말장난)를 이미징합니다. 우리는 유용하거나 바람직하지 않을 수도있는 우리 자신을 복제하는 것이 아니라 우리가 죽기 직전이나 직후에 자신을 복제 할 수있는 복제 기술을 갖게 될 것입니다. 우리는 새로운 몸을 위해 우리의 오래된 몸을 처분하고 새롭게 된 몸을 통해 영원히 살 수 있습니다.
생물학적 3D 프린터는 패러디 즘의 가장 중요한 기술 중 하나입니다. 그것은 우리가 영원히 살 수있을뿐만 아니라 우리가 필요로하는 음식과 필요한 모든 상품을 현장에서 만들 수있게 해줄 것입니다. 야채 나 소를 재배하는 데 많은 시간을 투자 할 필요가 없습니다. 3D 바이오 프린터는이 기사를 인쇄 할 수있는 것처럼 식사를 인쇄합니다. 지금까지 존재했던 모든 맛과 질감 중에서 선택할 수 있습니다.
전 세계 인터넷을 통해 연결된 모든 가정에 3D 바이오 프린터가있을 것이므로 새롭고 흥미로운 것이 나오면 모두가 인쇄하여 제조 및 운송으로 인한 지연없이 즐길 수 있습니다.
3D 바이오 프린터는 지속 가능한 풍요로운 사회를위한 해답이기도합니다. 모든 것이 생물학적 재료로 만들어지면 자연에 영향을 미치지 않습니다. 사용 후에는 모든 것이 퇴비화되고 원래 땅으로 돌아갑니다. 산더미 같은 쓰레기를 만들지 않고 사람들의 무한한 요구를 충족시킬 수있을 것입니다.
인류는 가장 중요한 노력으로 3D 바이오 프린터의 개발을 축하해야합니다. 언론은 거의 언급하지 않았습니다. 사실 그것은 세기의 가장 중요한 뉴스 중 하나입니다.
3D 바이오 프린터는 궁극적 인 패러디 스트 기술입니다. Paradism은이 기술을 최우선으로 생각합니다. 그것은 우리가 일하는 것에서 자유 로워지고 우리에게 필요한 모든 것을 거의 즉시 제공 할뿐만 아니라 풍요로운 영생을 가져올 것입니다. 우리는 먼지로 생명을 창조하는 신처럼 될 것입니다.
그것이 Paradism에 관한 모든 것입니다. 신들의 고향 인 낙원을 만듭니다.

.jpg)





댓글 없음
아름다운 덧글로 인터넷문화를 선도해 주세요